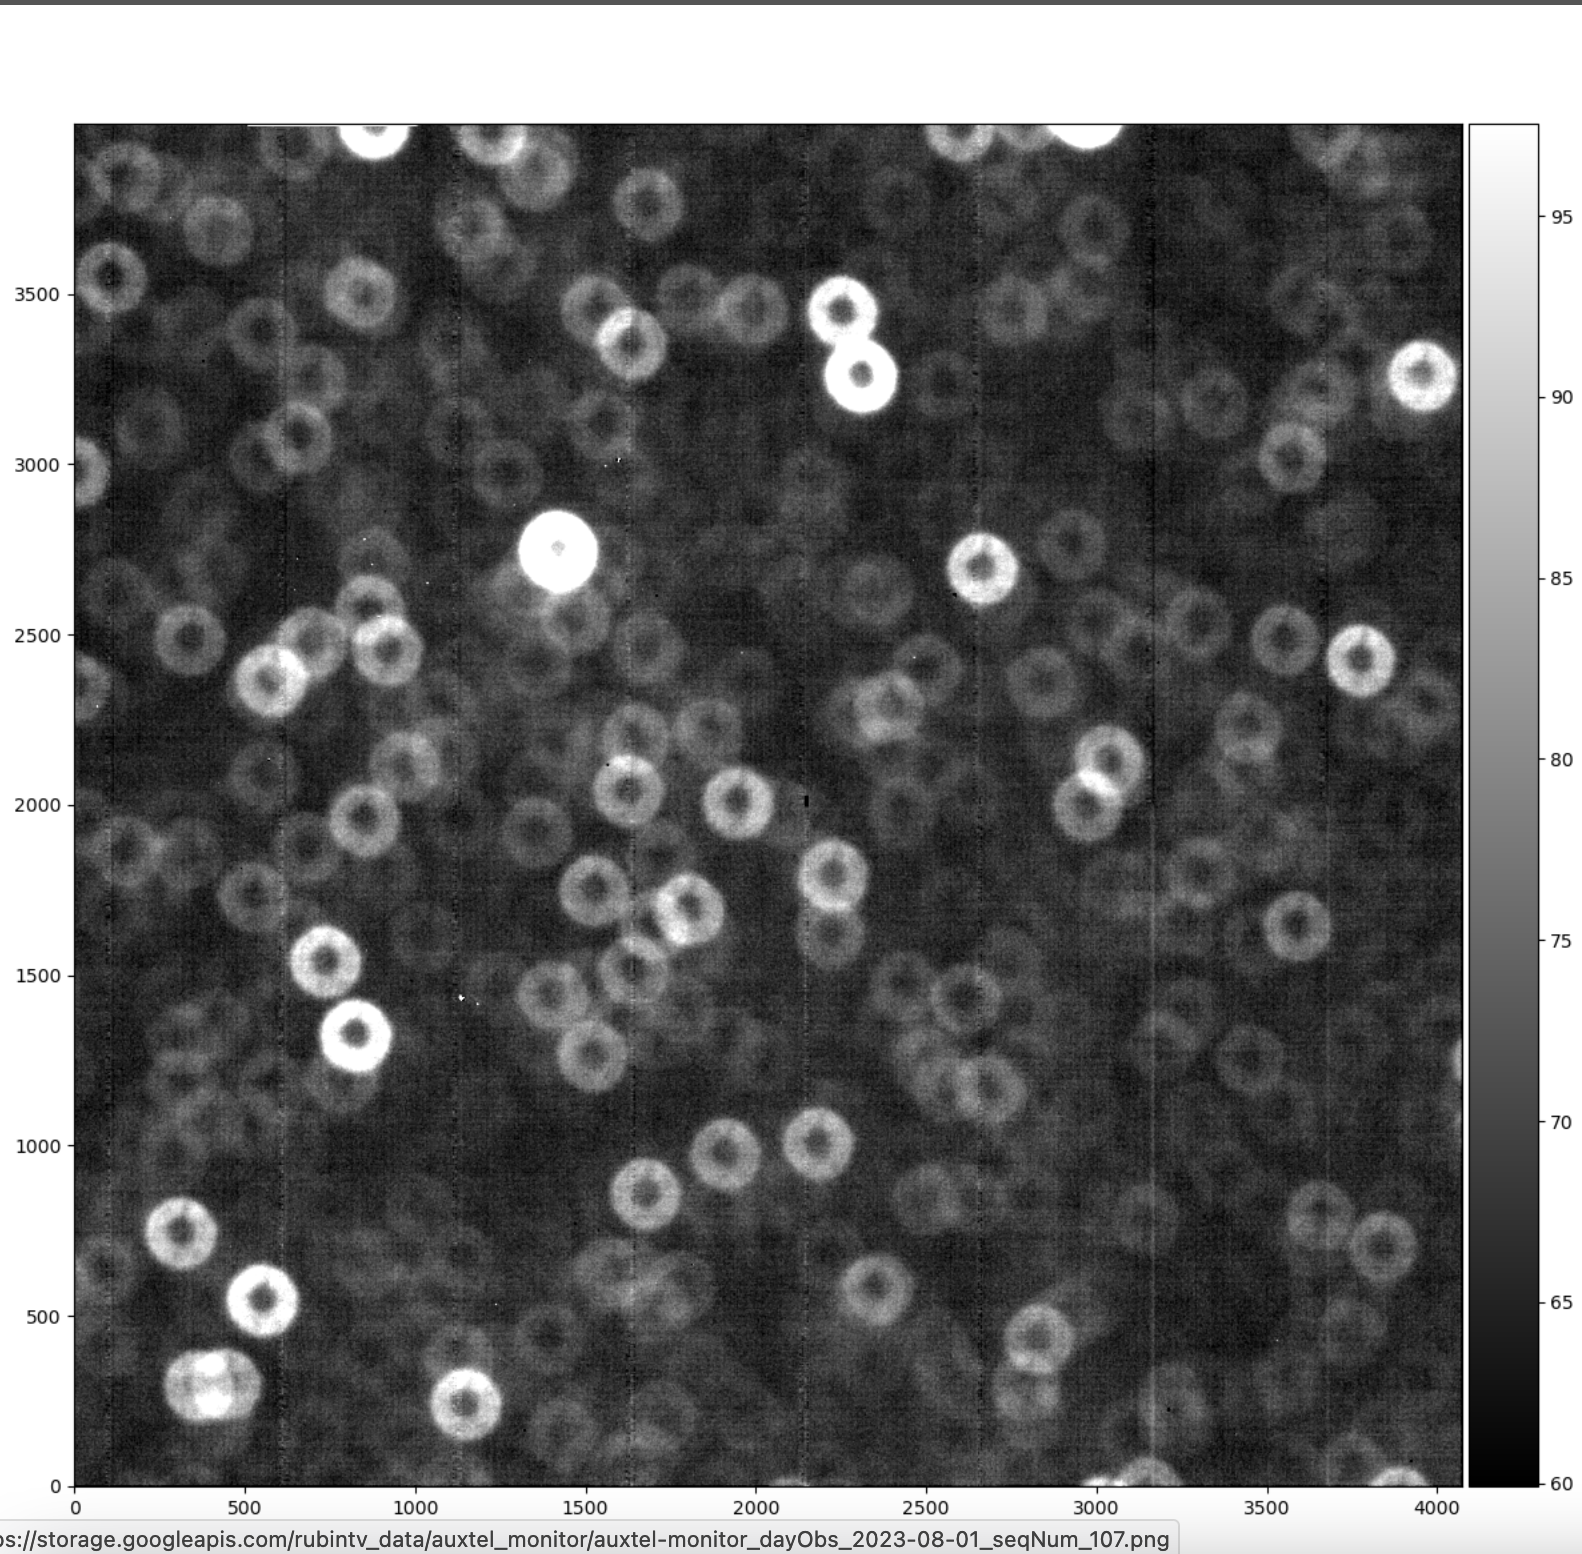

AuxTel Image out of focus¶
Overview¶
This procedure should be used when images appear out of focus due to a WEP failure or other related issues. Users will notice images ranging from slightly out of focus to large donut appearances when ATHexapod offsets are not correctly applied.
Error diagnosis¶
The focus script
auxtel/latiss_wep_align.pymight fail, leaving the system out of focus.These out of focus images might vary from slightly out of focus image when the LATISS WEP align script took the system out of focus, to complete out-of-focus images that can appear as large donuts when ATHexapod offsets are left in intra or extra focus positions due to a script failure.

Slightly out-of-focus image.¶
Extreme out-of-focus image.¶
Procedure Steps¶
Pause LOVE ATQueue.
Clear all ATAOS offsets for the x, y, and z axes. Load and run the standard script
auxtel/offset_ataos.pymoving the script up in the queue with the following configuration:auxtel/offset_ataos.py¶reset_offsets: all
Run the
auxtel/latiss_wep_align.pyexternal script with the configuration below to find a new target in the area of the sky of your choice. Replaceazandel.auxtel/latiss_wep_align.py¶find_target: az: 135 el: 40 mag_limit: 8.0
Keep playing the rest of the scripts in the queue, ensuring the system is now in focus.
Complete the procedure by verifying the system is in focus.
Post-Condition¶
System is back in focus.
Contingency¶
If the procedure was not successful, report the issue immediately in the #summit-auxtel channel.
If step 2 doesn’t work and you see a large number in the ATAOS offsets values at the AuxTel Monitor LOVE dashboard, it is because offsets had been wrongly accumulated.
Restart ATAOS: Cycle ATAOS CSC to
STANDBYand back toENABLEDstate.If ATAOS was restarted, corrections need to be re-enabled.
Use
run_command.pywith the following configuration to re-enable ATAOS corrections.run_command.pyto enable AOS corrections¶component: ATAOS cmd: enableCorrection parameters: hexapod: true m1: true atspectrograph: true